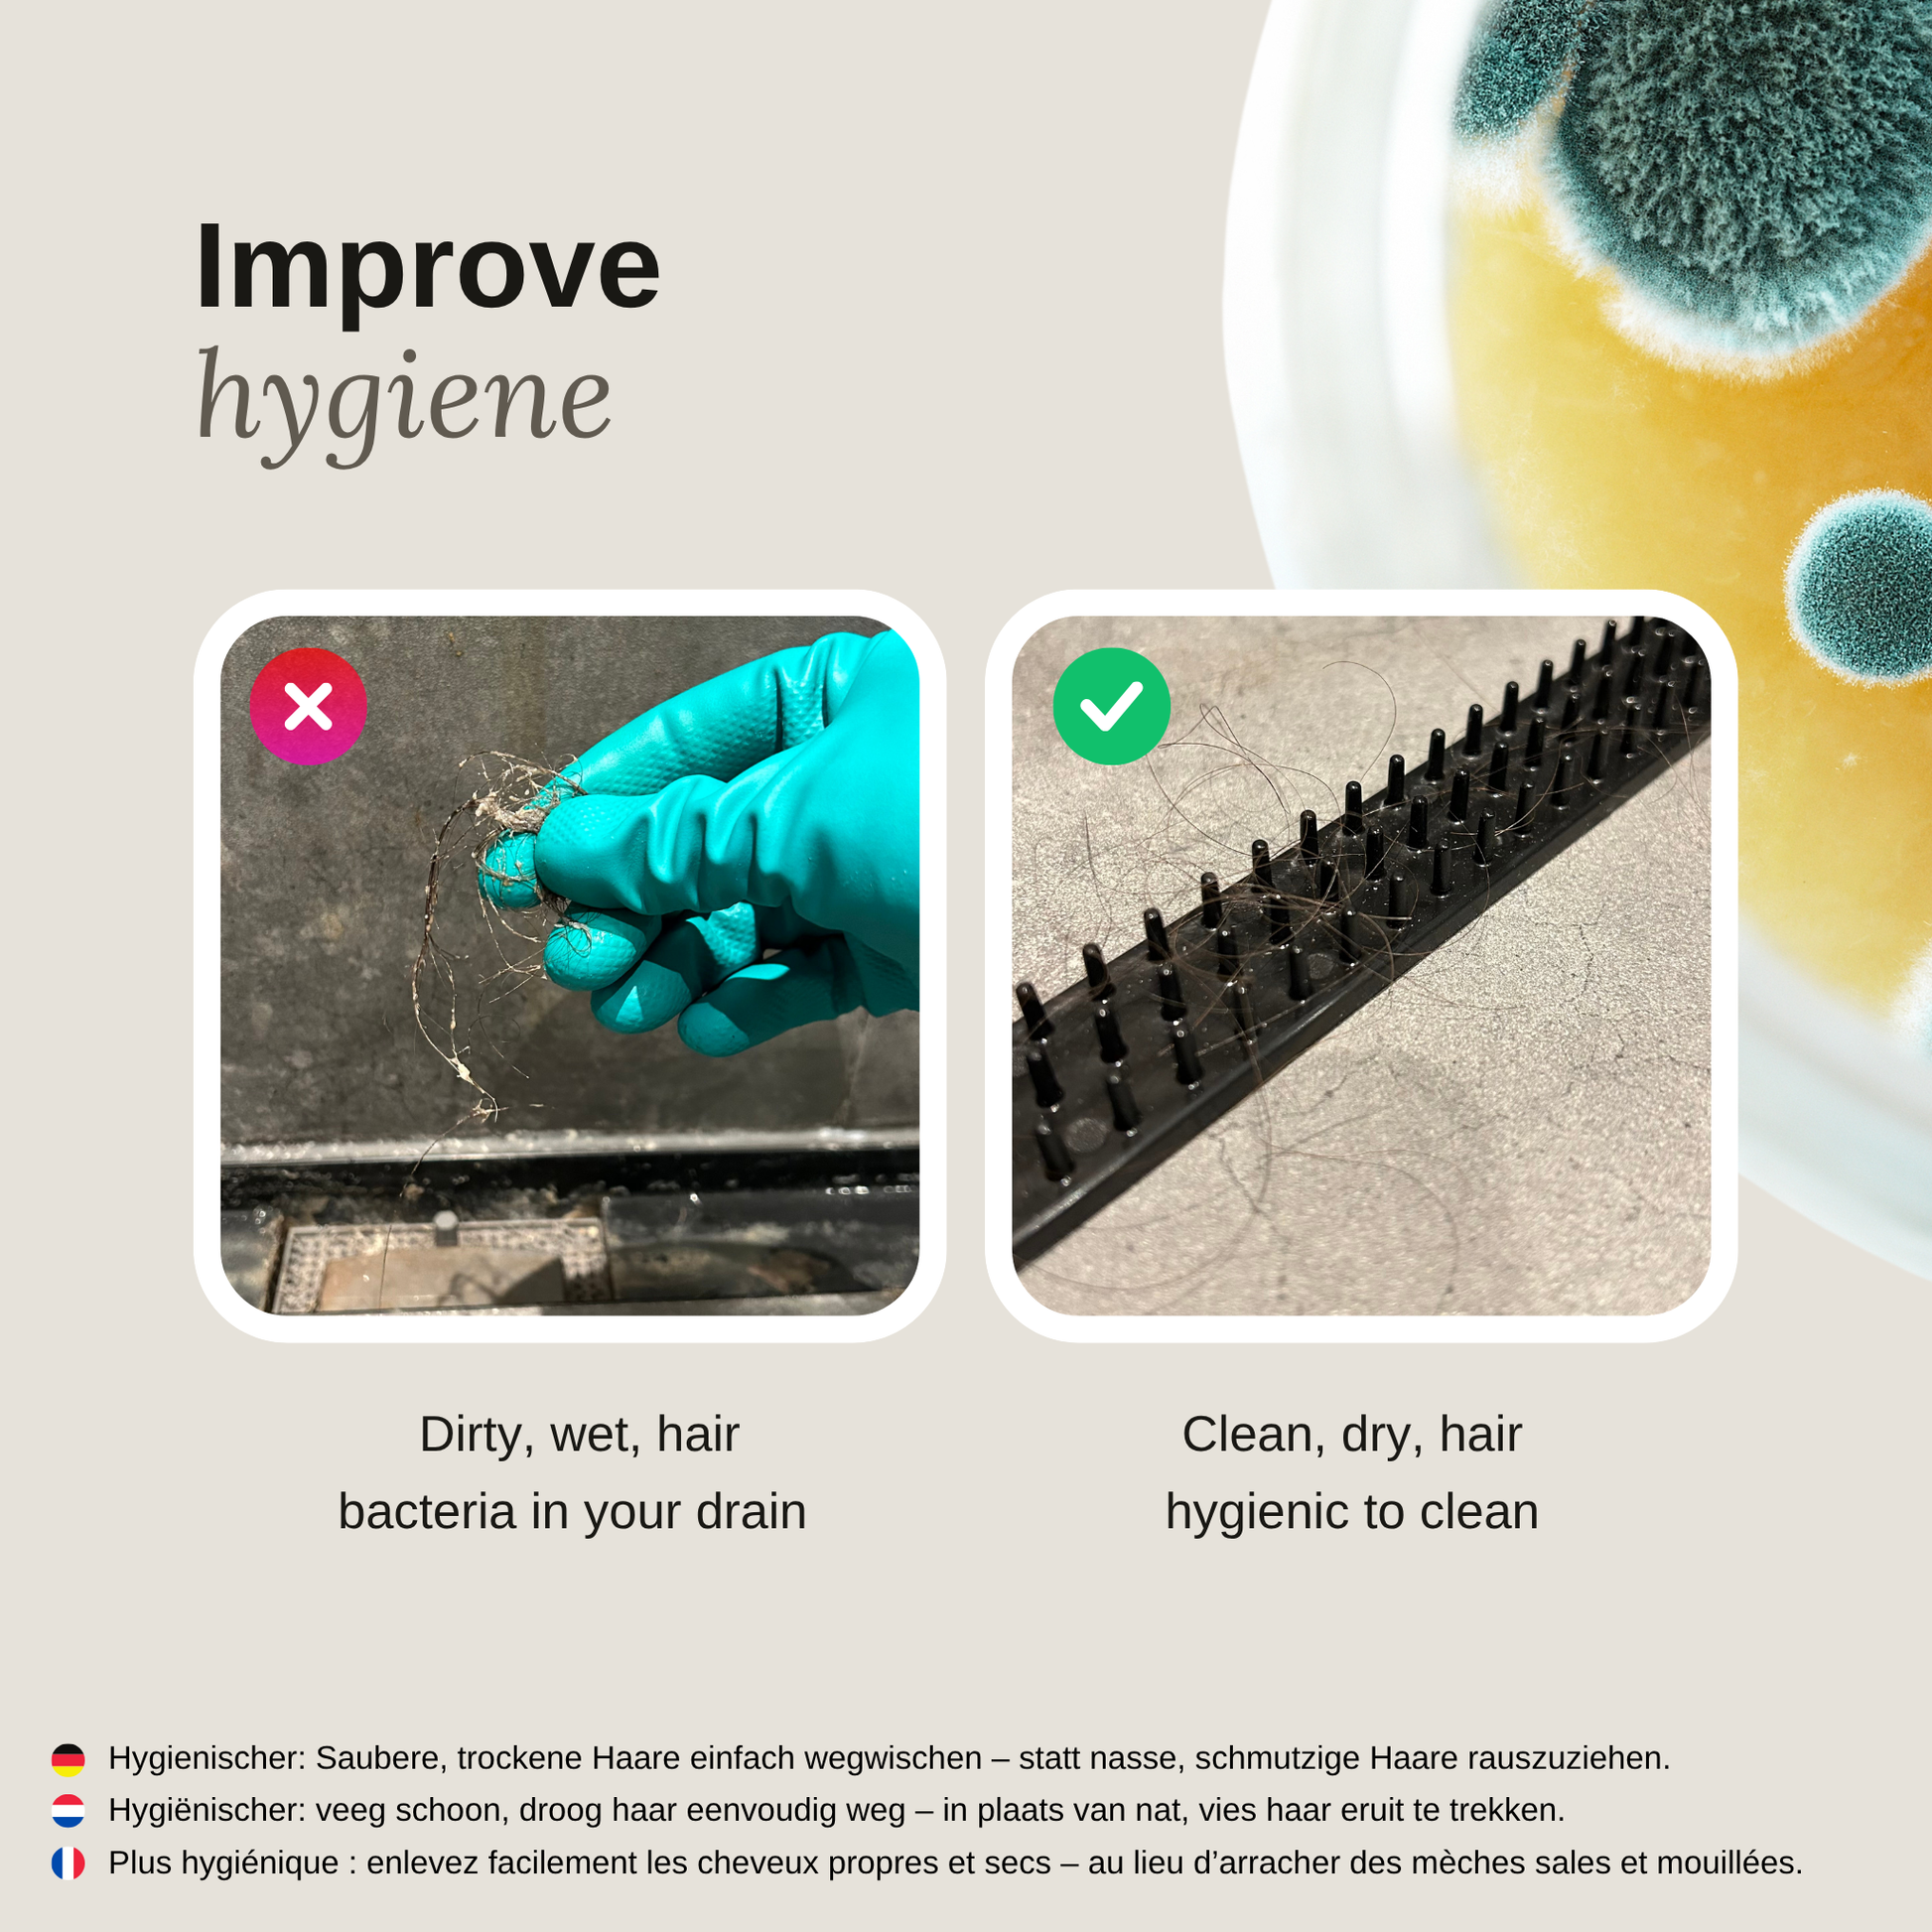
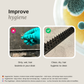

Draindodger Originele
Draindodger Originele
✅ 28 dagen geld-terug-garantie!
✅Vandaag besteld = Morgen al onderweg naar jou!
✅ Betaal veilig: iDEAL, Klarna, PayPal, Bancontact, creditcard
Kan beschikbaarheid voor afhalen niet laden
📞 Vragen of twijfels?
Klik hier voor een WhatsApp-gesprek: 06-57853369
- 🚚 Voor 23:00 besteld, gratis verzonden
- 🛒 Shop nu betaal later met Klarna
- 📦 28 dagen retourneren & geld-terug-garantie
- ✅ Levering gegarandeerd — en 5 jaar garantie als het stuk is
- ✅ Betaal veilig in 3 rentevrije termijnen met iDEAL in3 (beschikbaar voor klanten van ABN AMRO, ASN Bank, Bunq, ING, Rabobank, Regiobank en SNS)
Tired of cleaning your shower drain? Save yourself time, frustration and expensive plumber bills with draindodger.
- Prevents clogs: Catches hair before it reaches the drain.
- Less cleaning: No more hassle of disassembling the shower drain. Simply lift up draindodger, throw the hair in the trash, or vacuum it up.
-
More hygienic: Dispose of dry hair instead of removing wet and dirty hair.
-
Hidden comb: Can be used to easily remove hair or to connect multiple Draindodgers together for even greater results.
- Patented Dutch invention: High-quality and beautifully finished. Made from soft, flexible material that adapts to your floor and won't wash away.
Verzending
Verzending
Wij bieden Gratis verzending binnen heel Nederland en België.
Onze bestellingen worden binnen 24 uur verwerkt en verzonden!
Retourneren
Retourneren
Het is bij hollandse dingetjes.nl mogelijk om 14 dagen na ontvangst het product te retourneren.
Kwaliteits controle
Kwaliteits controle
Niet goed? Geld terug garantie!
Wij voeren op elke bestelling een kwaliteits controle uit. Dit zodat jij je geen zorgen hoeft te maken over je bestelde producten.
Klantenservice
Klantenservice
Heb je een vraag over je bestelling?
Ons klantenservice team staat klaar om jouw vraag binnen 12 uur te beantwoorden!